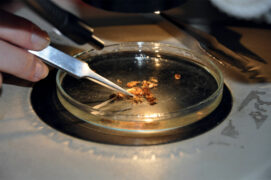

Christine Rollard désensibilise les arachnophobes
La spécialiste des araignées Christine Rollard aide les plus téméraires à surmonter leur arachnophobie. Coulisses d’une séance de désensibilisation au Muséum national d’histoire naturelle de Paris.
La spécialiste des araignées Christine Rollard aide les plus téméraires à surmonter leur arachnophobie. Coulisses d’une séance de désensibilisation au Muséum national d’histoire naturelle de Paris.
Coline fait partie des personnes qui ont décidé de faire confiance à l’arachnologue renommée. La jeune femme de 23 ans n’est pas rassurée pour autant et se touche nerveusement le bras. Elle balaie la pièce du regard pour détecter la présence éventuelle de l’animal qui cristallise ses angoisses. Un réflexe qui s’active chaque fois qu’elle arrive dans un nouvel endroit ou qu’elle rentre chez elle le soir. Aussi loin qu’elle se souvienne, la Parisienne a toujours été sujette à l’arachnophobie. Cela peut se manifester par des crises de panique à la vue de la moindre araignée. « Les petites qui restent dans leur coin, je gère encore. Mais dès qu’elles se mettent à bouger, ça ne va plus : je pleure, je hurle… », confie-t-elle. Dans le foyer familial, ses parents se sont toujours chargés d’éloigner les bestioles de sa vue. Alors qu’elle s’apprête à s’installer seule, Coline a décidé d’en finir avec cette phobie handicapante.
Quand, il y a quelques mois, l’étudiante l’a contactée, Christine Rollard a une fois de plus accepté bénévolement ce qu’elle estime être sa mission. Par la même occasion, l’arachnologue espère réhabiliter la réputation de ces animaux souvent victimes de notre ignorance. L’engagement de celle que l’on surnomme Mme Araignée a fait ses preuves : en plus de trente ans, environ 90 % de ses visiteurs sont parvenus à laisser leurs démons au vestiaire. Son secret ? Ni hypnose ni psychothérapie et encore moins de la magie. Christine Rollard a développé une approche progressive, rationnelle et basée sur l’acquisition de connaissances : c’est quoi une araignée et comment ça vit ? Le tout concentré sur une ou deux séances de trois à cinq heures.
Assise entre la biologiste et son père venu la soutenir, Coline redoute le déroulé de l’après-midi. Christine la met à l’aise : « Tu es venue jusqu’ici et c’est déjà un sacré pas, bravo ! La prochaine étape, c’est d’accepter l’idée qu’on va parler de ce qui te fait peur. On redoute moins ce qu’on connaît. Respire, détends-toi… Maintenant, dis-moi ce qui t’effraie chez les araignées. » Coline raconte son épouvante lorsque, en colonie, elle s’était réveillée avec une grosse bête sur la jambe et d’autres souvenirs traumatiques.
“J’ai surtout peur des grosses, celles qui vont vite et me sautent dessus.
„
Question de culture
Non, la peur de l’araignée n’est pas ancestrale ni instinctive. Elle est culturelle. Sinon, comment expliquer que l’arachnophobie se cantonne surtout aux pays occidentaux ? Ailleurs, comme en Asie, en Afrique ou en Amérique du Sud, cet animal n’effraie personne. Il est même apprécié à la maison pour ses qualités de chasseur d’insectes et se retrouve donc associé à une symbolique positive. Ainsi, la petite tisseuse représente la chance et la richesse en Chine. Elle est un personnage facétieux dans les contes africains et vénérée comme créatrice de l’Univers chez certains Indiens d’Amérique du Sud.
Une boule et huit pattes
L’arachnologue constate, comme souvent, que l’aversion de sa patiente est basée sur des représentations infondées. Elle commence donc par rétablir quelques réalités scientifiques : « A ton avis, c’est quoi la taille moyenne d’une araignée ? » La jeune femme forme un gros cercle avec ses doigts. « Eh non ! Entre 5 mm et 1 cm de longueur de corps seulement, lance l’enseignante. Bien sûr, on peut lire sur Internet que la plus grosse du monde, l’araignée Goliath de Guyane, fait 30 cm. Or, elle est mesurée pattes tendues, ce n’est pas une position naturelle et c’est justement pour faire peur. »
« Ah bon ? » Coline va de surprise en surprise. « Tu verras, tu en sauras bien plus sur cet animal que la plupart des gens et c’est toi qui pourras les rassurer ! Transmettre fait partie de la thérapie », assure la chercheuse. Contre toute attente, l’étudiante s’enthousiasme à cette idée. On dirait que quelque chose en elle s’est déjà débloqué. Elle commence à réaliser que les araignées ont leur place sur cette Terre, vu qu’elles existent depuis 305 millions d’années, soit près de 100 millions d’années avant les dinosaures. Hormis les calottes polaires, elles ont colonisé tous les milieux terrestres, du fond des grottes souterraines jusqu’au massif de l’Everest à 6 700 m d’altitude. « Ouah, respect », déclare l’élève attentive.
La femme de science sort une feuille de papier et demande à Coline et à son père de dessiner une araignée. La jeune femme esquisse une boule avec huit pattes toutes droites et une tête pourvue de six yeux globuleux. Elle sourit, se doutant que la réalité est sûrement tout autre. Christine confirme : « On va partir du schéma de ton père, un peu plus réaliste, et l’enrichir de plein d’informations. »
Tout en griffonnant, l’experte confirme que ces animaux ont huit pattes, ce qui les différencie des insectes, et qu’elles sont rattachées à l’avant d’un corps en deux parties. Ils sont dotés de filières productrices de soie à l’arrière et de crochets à l’avant, etc. La professeure en profite pour casser les fausses idées qui ont la peau dure. La volontaire ne manifeste plus aucun signe physique de stress et pose des questions. Même le dessin final, pourtant devenu extrêmement réaliste, ne l’effraie pas ! La spécialiste tente alors de lui montrer des photos d’araignées et des peluches. Tout va bien, on dirait. Passons à l’étape suivante.
Le labo de Spider-Woman
La passionnée emmène la jeune femme à l’entrée de son laboratoire. « Il va falloir que tu acceptes la présence d’araignées tout autour de toi. C’est un bon exercice, car, comme tu le sais, ces animaux sont omniprésents, même si tu ne les vois pas ou que tu préfères les ignorer. Et si tu paniques, pense à tout ce que tu viens d’apprendre. Ces animaux ne te veulent aucun mal. Tu es tellement grande qu’ils ne peuvent absolument pas t’envisager comme une proie. » Coline respire un bon coup et suit sa thérapeute à l’intérieur. La porte s’ouvre sur un bureau, digne d’un Professeur Tournesol version arachnologue. Les tisseuses à huit pattes sont partout : sur des photos, des posters anatomiques et dans des dizaines de bocaux soigneusement étiquetés. Clou du spectacle, il y en a des bien vivantes en terrarium ! La jeune femme se raidit, mais fait tout de même le tour du lieu en faisant craquer le vieux plancher sous ses pas. « Tu vois ce bocal avec de minuscules bêtes conservées dans l’alcool, c’est un chercheur qui l’a sorti pour son étude. Es-tu capable de le prendre dans les mains ? demande la scientifique. Va à ton rythme. Je ne fais que proposer et tu décides. » Comme l’élève s’exécute avec curiosité, l’experte lui propose d’aller plus loin en observant ces minuscules dépouilles sous la loupe binoculaire. « OK ! »
L’étudiante colle prudemment ses yeux contre les deux optiques. « Ouh là ! C’est agressif en tout grand ! », s’exclame-t-elle dans un mouvement de recul. L’arachnologue lui conseille d’être active dans son observation : «Fais bouger les corps dans la boîte de Petri, observe-les. Vois comment sont les deux parties du corps, les pattes… » Cette fois, la scientifique en herbe fait l’effort d’aller à la rencontre de ces êtres si différents des mammifères que nous sommes. « Ah ouais ! C’est marrant de voir leurs yeux de si près. Je ne les imaginais pas comme ça, déclare-t-elle. Ces bêtes sont magnifiques avec leurs jolis dessins, mais je ne vais pas vous mentir, je les préfère mortes. »
Une douceur surprenante
La thérapie ne va pas s’arrêter en si bon chemin. L’une des choses qui effraient le plus Coline, c’est le contact avec l’animal. Mme Araignée aimerait lui prouver le contraire en lui faisant toucher une mue de mygale de Guyane. « Tu verras, c’est doux comme une peluche. Son corps est recouvert de sortes de poils qu’on appelle soies, éclaire l’experte. C’est pareil pour toutes les araignées, mais c’est difficile de le sentir sur des petites », explique-t-elle. La Parisienne se frotte à nouveau les bras, ce que lui fait immédiatement remarquer son accompagnante, puis elle se jette à l’eau. D’abord une petite caresse doublée d’un sursaut et hop ! Elle saisit la mue. Verdict : « C’est plutôt agréable. » La chercheuse savoure cette première victoire. « C’est normal, ces petites réactions. On ne va pas te les enlever en une fois. Mais dès que la surprise est passée, entraîne-toi à ne plus l’associer à la peur en mobilisant tes nouveaux acquis », encourage-t-elle. Et d’ajouter : « Personne ne te demande d’aimer les araignées, mais au moins de les accepter comme elles sont, dans ton environnement, pour t’éviter des crises de panique. »
“Elles sont magnifiques...mais je ne vais pas vous mentir, je les préfère mortes.
„
Tout un cinéma
La vision négative qu’ont les Occidentaux de l’araignée est entretenue par leur relative déconnexion à la nature, mais aussi par des mythes et croyances. La Bible transmet par exemple une image plutôt négative de l’arachnide et de sa toile, contrairement au Coran. Ces représentations sont sans cesse entretenues par la littérature ou le cinéma. Hormis dans Spider-Man, l’animal y est souvent représenté comme un être maléfique et répugnant. Qui n’a pas tremblé devant les monstres fabulés d’Arac Attack, d’Harry Potter ou du Seigneur des anneaux ?
Un alien en liberté
A présent, l’enseignante propose d’observer une bête vivante en mouvement, ce qui révulse encore la jeune femme. D’abord une petite zoropse à pattes épineuses dans un tube. « C’est une espèce que l’on rencontre dans les habitations comme la tégénaire, donc une potentielle colocataire, présente la professeure. Sa mère avait pondu dans ce coin et les bébés se sont dispersés pendant la nuit. Je l’ai capturée pour toi. Tu veux la voir sous la binoculaire ? » Coline réalise qu’il y a une centaine de bestioles en liberté dans la pièce, mais reste calme. « Ouh là là, ça bouge à toute vitesse ! Mais en fait, elle est marrante… presque mignonne », rigole-t-elle.
« C’est très bien, félicite l’arachnologue. On essaie avec quelque chose d’un peu plus gros ? Des pholques, on les rencontre aussi chez nous. » L’étudiante veut continuer sur sa lancée, mais ces fines bestioles à longues pattes l’enchantent nettement moins. Elles lui font penser à un alien ou aux personnages longiformes de Tim Burton. Pour la ramener dans le réel, Christine lui propose une astuce pour différencier le mâle de la femelle : « Tu vois, le mâle a des espèces de gants de boxe sur sa première paire de pattes, on les appelle bulbes copulateurs. C’est valable pour toutes les espèces. » Ça fonctionne, l’appréhension fait place à une observation apaisée. Les présentations étant faites, la thérapeute propose une rencontre en liberté. Après un temps d’hésitation, la jeune femme donne son feu vert. Toutes deux s’assoient à une table et Christine libère l’animal qui tente de prendre ses huit pattes à son cou. Coline se lève en hurlant, tétanisée. « Respire ! C’est normal, il fallait que tu aies cette réaction devant moi, tu étais encore trop dans ta zone de confort », rassure l’experte. La courageuse rit nerveusement : « J’ai peur qu’elle me fonce dessus ! » « Non, les araignées n’ont aucun intérêt à grimper sur nous. Nous leur servons parfois de support, mais ça ne t’effraie pas quand un papillon ou une coccinelle fait de même… » Pour prouver ses dires, la biologiste essaie de contraindre le pholque à escalader sa main, ce qu’il évite immédiatement. « Tu vois, il va toujours fuir, jamais il ne viendra vers toi volontairement. En plus, comme toutes les araignées, il n’a pas beaucoup d’endurance et s’arrête » . La jeune femme se rend compte qu’elle n’a rien à craindre et se rassoit.
Yo-yo de soie
Encouragée par l’arachnologue, Coline franchit encore un cap en posant sa main au centre du carton. « Je suis prête », affirme-t-elle. Christine guide alors le petit mâle vers sa peau. Et là, aucun mouvement de recul, aucun cri, même pas une grimace. « Ça chatouille un peu », rigole Coline qui n’en croit pas ses yeux. Après plusieurs passages, l’experte lui suggère de prendre l’araignée dans ses mains. Sentant qu’elle s’élève en hauteur, la petite bête colle un invisible point d’accroche en soie sur sa main et descend en rappel le long de son fil. Cela amuse beaucoup la Parisienne qui rattrape la soie à mesure qu’elle sort des filières, comme un yo-yo. La chercheuse lui fait remarquer que l’araignée contrôle la vitesse de sa descente en bloquant le fil avec les griffes de ses pattes arrière. « Bravo ! Est-ce que tu te rends compte de ce que tu as accompli en trois heures ? se réjouit la mordue d’arachnides. Ancre bien cette expérience et la fierté ressentie dans ta mémoire. Tu as coupé le fil de la peur et désormais tu te souviendras de cette expérience positive. » Pour terminer, l’arachnologue lui donne un dernier exercice qui lui servira à la maison : attraper l’araignée avec un bol, glisser un carton fin en dessous et la déplacer à un endroit où elle ne dérangera personne. « Pas à l’extérieur, insiste-t-elle, ne lui change pas son mode de vie. » La jeune femme exécute cette tâche sans peine. Ce n’est rien du tout, comparé à ce qu’elle vient de faire ! « Jusque-là, ce sont tes parents qui le faisaient pour toi. Mais maintenant, tu en es capable ! On ne peut guérir une phobie que si on s’y confronte régulièrement », prévient Christine. L’étudiante s’engage à s’entraîner à la maison, mais savoure d’abord sa première victoire : « Je suis épuisée, mais tellement heureuse. Je n’aurais jamais pensé relever autant de défis aujourd’hui. »
“Elles ne sont pas si effrayantes. Ce sont des animaux comme les autres.
„
Peur contagieuse
Phénomène récent qui entache la réputation de l’araignée : les informations fausses ou largement exagérées qui circulent sur Internet. La relative méconnaissance de la bestiole pousse à croire ces contenus anxiogènes et à les partager. En même temps, des émissions et articles dédiés à l’arachnophobie se multiplient, créant une sorte d’emballement. Et plus on en entend parler, plus on est enclin à en souffrir.

Christine Rollard
Biologiste experte des araignées, Christine Rollard est enseignante-chercheuse au Muséum national d’histoire naturelle de Paris. Depuis plus de trente ans, elle propose bénévolement des séances de désensibilisation. Elle est aussi coauteure, avec le psychologue A. Mokeddem, du livre Je n’ai plus peur des araignées, Dunod, 2018.

La Salamandre s'associe à Baleine sous Gravillon, les podcasts du vivant, pour une série de six entretiens avec Christine Rollard sur le monde fascinant des araignées.

Cet article fait partie du dossier
Les araignées, huit pattes, un monde !
-
Photos
Photos10 idées reçues sur les araignées
Abonnés -
Sciences
SciencesChristine Rollard désensibilise les arachnophobes
Abonnés -
Sciences
SciencesL’anatomie d’une araignée en détail
Abonnés -
Sciences
SciencesComment l’araignée ressent-elle son environnement ?
Abonnés -
Sciences
SciencesPourquoi et comment l’araignée tisse-t-elle sa soie ?
Abonnés -
Sciences
SciencesComment les crochets des araignées fonctionnent-ils ?
Abonnés -
Sciences
Sciences3 technologies inspirées des araignées
Abonnés -
Photos
PhotosUne année à la découverte des araignées
Abonnés -
Dessins Nature
Dessins Nature18 araignées à voir tout au long de l’année
Abonnés -
Photos
PhotosLes gagnants du grand concours photos sur les araignées

Cet article est extrait de la Revue Salamandre
Catégorie
Ces produits pourraient vous intéresser
Poursuivez votre découverte
La Salamandre, c’est des revues pour toute la famille
Plongez au coeur d'une nature insolite près de chez vous
Donnez envie aux enfants d'explorer et de protéger la nature
Faites découvrir aux petits la nature de manière ludique
merci de ne pas les utiliser sans l'accord de l'auteur